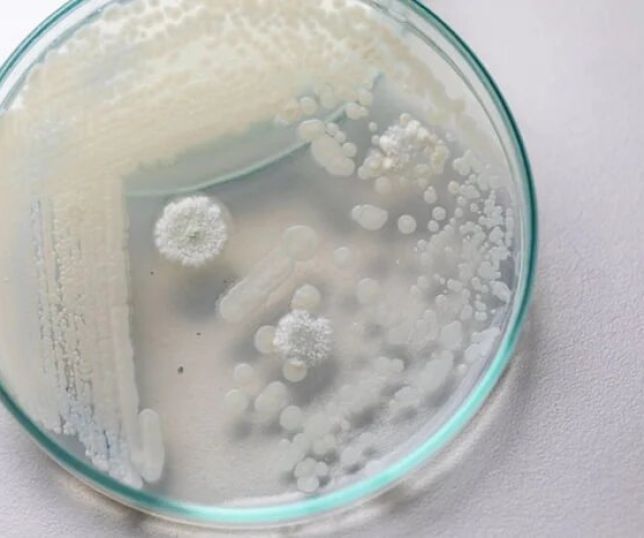

Três estados da região Norte - Amapá, Roraima e Pará - registram tendência de aumento na internação de crianças pequenas por vírus respiratórios nas últimas seis semanas. A informação está no Boletim InfoGripe, acompanhamento semanal feito pela Fundação Oswaldo Cruz (Fiocruz).
Os casos de Síndrome Respiratória Aguda Grave (SRAG) identificados pelo estudo, divulgado na última quinta-feira (18), são causados principalmente pelo vírus sincicial respiratório (VSR) e rinovírus.
O VSR acomete com muita frequência os primeiros meses de vida dos bebês e leva a casos como bronquiolite, doença que começa com febre, tosse, igual a outras doenças respiratórias, mas que progride para um quadro de cansaço e insuficiência respiratória.
Veja também
Fungo resistente que nunca tinha sido visto em humanos mata 2 pessoas
O boletim da Fiocruz destaca ainda que estados do Sudeste, à exceção do Rio de Janeiro, apresentaram nas últimas seis semanas tendência de alta no número de internações para tratamento de infecções causadas pelos vírus influenza (gripe), vírus sincicial respiratório e rinovírus.
No entanto, o levantamento identifica que no país como um todo, há a manutenção da tendência de queda nos casos. A análise abrange dados até a semana epidemiológica 28, de período de 7 de junho a 13 de julho.
A Fiocruz aponta que a covid-19, causada pelo vírus Sars-CoV-2 circula no país em níveis baixos, porém, em se tratando de idosos, é a primeira causa de internação por SRAG e segunda maior causa de mortes por SRAG. A análise registrou leve aumento da atividade da covid-19 em alguns estados do Norte e Nordeste, com destaque para Ceará, Piauí e Amazonas.
A Fiocruz reforça a importância da vacinação contra a covid-19 e influenza por todas as pessoas elegíveis. Nas últimas quatro semanas epidemiológicas, o VSR é o maior causador de internação por SRAG, com 38,8% dos casos, seguido pelo Influenza A (21,5%), covid-19 (8,7%) e Influenza B (1%). Já em relação às mortes, a principal causa é o Influenza A, com 40,7% dos casos, seguido pelo Sars-CoV-2 (26,2%).
No ano, o Brasil tem 97.469 casos de SRAG, sendo 47.401 (48.6%) com resultado laboratorial positivo para algum vírus respiratório. O maior causador é o VSR, com 45% das notificações. Cerca de 7,6 mil casos esperam resultado laboratorial.
Curtiu? Siga o PORTAL DO ZACARIAS no Facebook, Twitter e no Instagram.
Entre no nosso Grupo de WhatApp, Canal e Telegram
Em relação a mortes registradas por SRAG, são 5.982, sendo 3.243 (54.2%) com resultado laboratorial positivo para algum vírus respiratório. O vírus maior causador de óbitos é o da covid-19, representando 55% dos casos.
Fonte:Agência Brasil